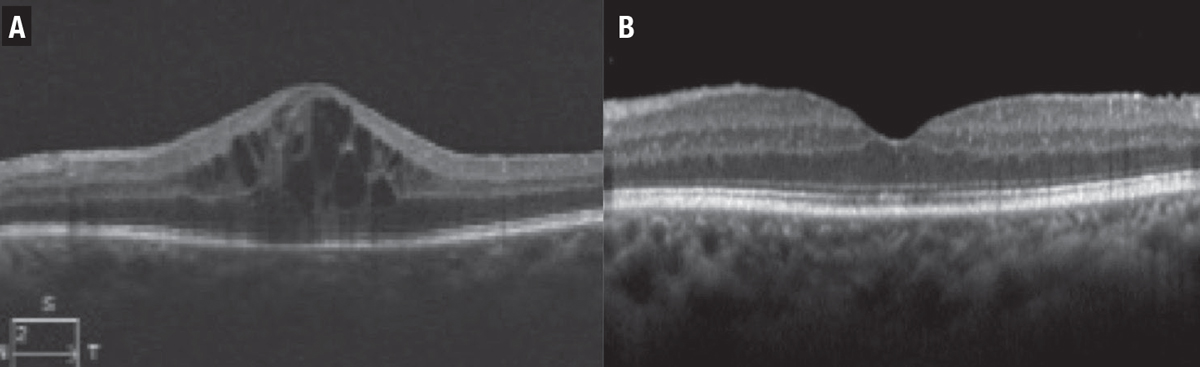
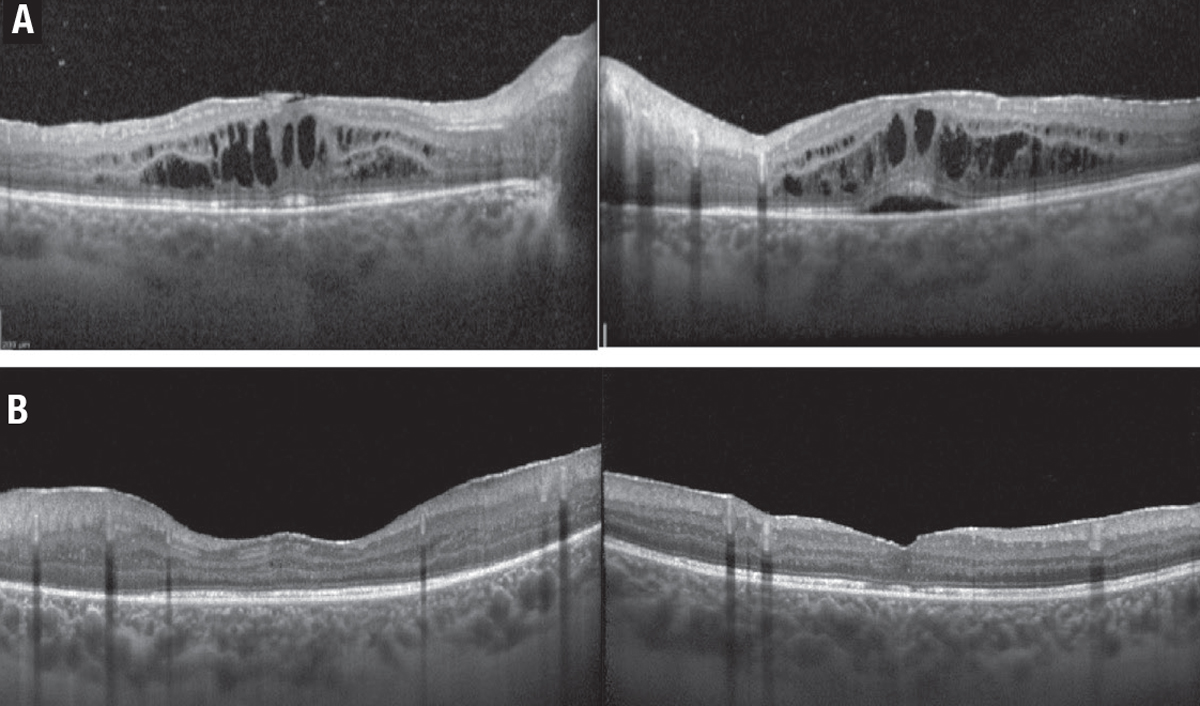
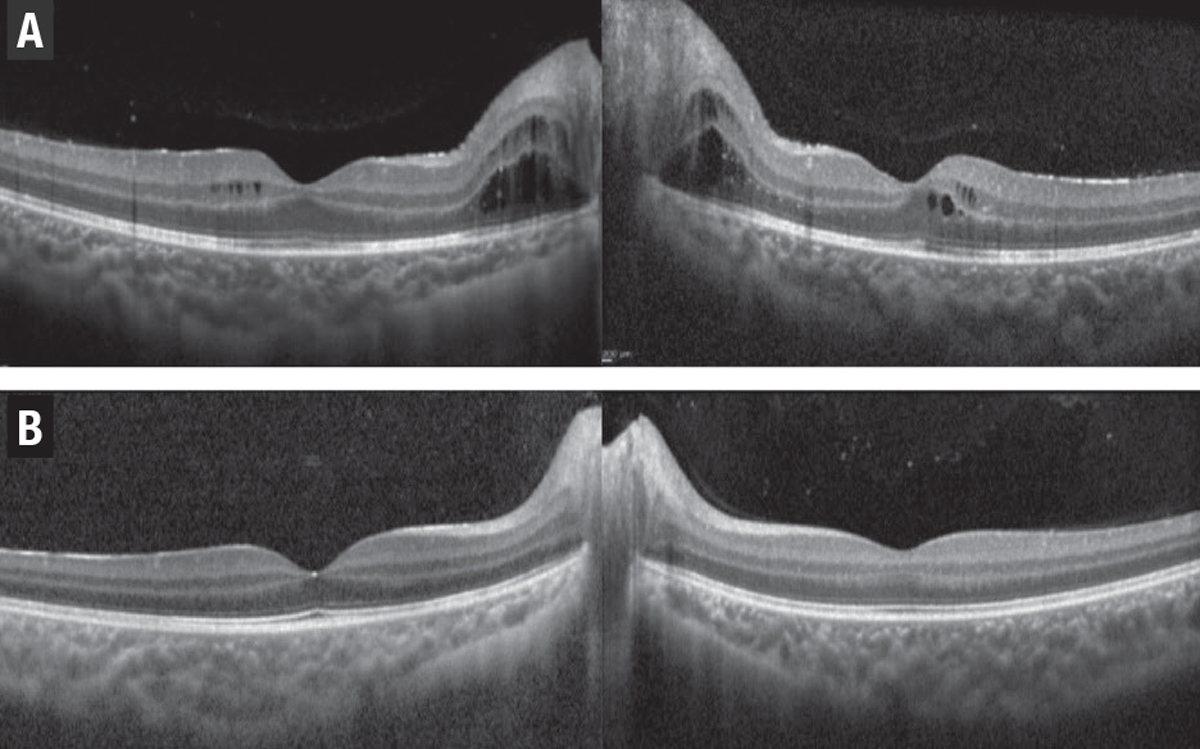
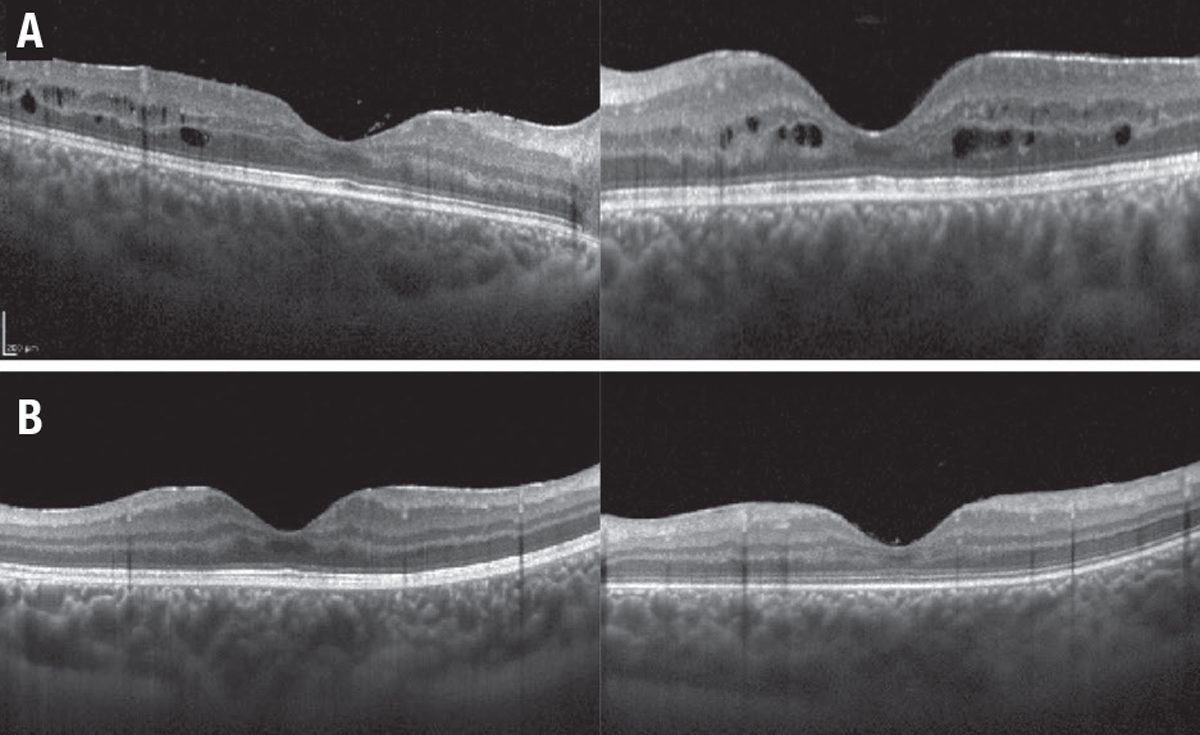

|
|
Bio DISCLOSURE: Dr. Emami- Naeini has no relevant financial disclosures. |
Uveitis is one of the major causes of vision loss among young, working- age people.1 Visual impairment is noted in 70 percent of patients with noninfectious uveitis, with macular edema the most common etiology.1,2 In these patients, inflammation leads to impairment of the blood-retinal barrier and increased permeability of chorioretinal vasculature, which will result in accumulation of fluid and uveitic macular edema (UME).3 Macular edema can be seen in any type of noninfectious uveitis, but it’s most commonly seen in association with intermediate, posterior or panuveitis.
Fluorescein angiography and optical coherence tomography are used to confirm the presence of vascular leakage and macular edema. Based on the location of fluid on OCT, UME can be classified into cystoid macular edema, diffuse macular edema and serous retinal detachment. Of these, diffuse edema is the most common, and cystoid macular edema has the most impact on patient’s vision.4,5
Chronic, untreated UME may result in damage to photoreceptors and permanent vision loss. Moreover, UME can be seen even in the setting of controlled uveitis as well as a result of previous inflammation and permanent damage to the blood-retinal barrier.6 Several systemic and local treatment options are available for UME, which we’ll review here.
|
| Figure 1. A) A 68-year-old woman with a history of sarcoidosis presented with leakage and uveitic macular edema (UME) in the left eye. B) After treatment with intravitreal triamcinolone acetonide, the UME resolved six weeks later. |
Local treatments
Local treatments fall into two subcategories: topical eye drops, and peri- and intraocular steroids.
Eye drops have been used extensively to control anterior uveitis. Recent studies have shown favorable intraocular penetration and effectiveness of various topical drops in the control of UME. Non-steroidal drops, including bromfenac, nepafenac and ketorolac, and steroidal drops, including prednisolone acetate and difluprednate, have been successfully used to treat UME. Corticosteroid drops have been associated with an increase in intraocular pressure and cataract formation. However, they seem to have fewer side effects than other treatment modalities.7,8
A number of peri- and intraocular steroids are available. They include:
- Triamcinolone acetonide 40 mg/ml. Preservative-free triamcinolone acetonide (Triesence, Novartis) is injected intravitreally and has shown to be effective for six to eight weeks, less in vitrectomized eyes. Sub-Tenon’s or transseptal injection of preserved triamcinolone acetonide (Kenalog, Bristol-Myers Squibb) provides a depot of slowly releasing steroids for two to three months. However, the duration is less predictable because of triamcinolone’s variable particle size.
- Dexamethasone 0.7-mg implant. It’s approved for intravitreal use in patents with uveitis and the effect lasts for three to six months. The POINT trial of Ozurdex (Allergan/AbbVie), a prospective randomized clinical study with intravitreal and periocular triamcinolone, showed that both intravitreal steroids are more potent than the periocular steroid in controlling UME and improving visual acuity, with a modest increase in intraocular pressure. No statistically significant difference was found between the two intraocular steroids9 (Figure 1).
- Fluocinolone acetonide 0.18-mg injectable implant. This implant (Yutiq, EyePoint Pharmaceuticals) has shown effectiveness in controlling intraocular inflammation, decreasing flares and preventing vision loss in patients with posterior uveitis.10 The fluocinolone acetonide 0.19-mg implant (Iluvien, Alimera Sciences) is a similar steroid with slightly different dosing. It’s approved for use in diabetic macular edema in the United States and Europe, and for noninfectious uveitis in Europe.11 Studies have demonstrated its effectiveness in managing UME.12
-
Fluocinolone acetonide 0.59-mg surgical implant. Surgically sutured to the sclera, this implant (Retisert, Bausch + Lomb) can slowly release steroids over approximately 30 months. Its safety and efficacy have been widely studied in the landmark MUST trial and follow-up publications.13 In this prospective, multicenter trial patients with non-infectious intermediate, posterior or panuveitis were randomized to receive the Retisert implant or were managed with systemic immunosuppressive therapy. The seven-year follow-up data showed that the implant was effective in controlling inflammation. However, patients who received systemic treatment had better visual outcomes at seven years but with high rates of cataracts and glaucoma surgery in the implant group (Figure 2).
Figure 2. A) A 24-year-old woman with a history of ulcerative colitis and panuveitis was diagnosed with uveitic macular edema (UME), which failed to respond to systemic immunosuppressives. B) The fluocinolone acetonide 0.59-mg surgical implant (Retisert, Bausch + Lomb) resulted in resolution of the UME within two months after surgery.
- Suprachoroidal triamcinolone acetonide injectable suspension. This implant (Xipere, Clearside Biomedical and Bausch + Lomb) recently received Food and Drug Administration approval for use in patients with UME.14 The efficacy and safety of this platform in UME have been studied in the Phase III PEACHTREE trial.15 In this study, 47 percent of patients who received the suprachoroidal steroid gained >15 letters compared to only 16 percent in the sham group (p<0.001). The drug was well-tolerated with comparable rates of cataract and elevated intraocular pressure between the treatment and control arms.
- Anti-VEGF. Recent studies have shown that these medications can be effective in UME, as well. Ranibizumab (Lucentis, Genentech) and aflibercept (Eylea, Regeneron Pharmaceuticals) have been used successfully in treating refractory UME.16
Systemic treatments
Corticosteroids are effective in controlling ocular inflammation, retinal vasculitis and UME. Their use is associated with a lower risk of local side effects, such as glaucoma and cataract. However, high rates of systemic side effects, including hypertension, diabetes, osteoporosis, mood changes, increased risk of infections and more limits their long-term use. Systemic corticosteroids are generally used for a short period of time and to control acute or breakthrough inflammation.
So, steroid-sparing immunosuppressives are an option for longer-term therapy. They include:
-
These agents include mycophenolate mofetil (Cellcept, Genentech/Roche) and methotrexate, both of which are commonly used as first-line steroid-sparing immunosuppressives in patients with uveitis, and are effective in controlling UME. The FAST trial compared the efficacy of these two medications.17 This prospective, randomized trial showed that methotrexate is more effective in controlling posterior and panuveitis, and favored mycophenolate in controlling intermediate uveitis. The subanalysis of study data on patients with UME showed that both medications can reduce macular edema.18 However, half of the eyes had persistent edema at 12 months. Side effects include increased risk of infection, liver failure and fatigue.
Figure 3. A) A 9-year-old boy had panuveitis and macular edema in both eyes despite topical drops. B) The macular edema resolved three months after the patient started systemic therapy with methotrexate and adalimumab (Humira, AbbVie).
- Adalimumab. This tumor necrosis factor (TNF) inhibitor (Humira, AbbVie) is a fully human monoclonal antibody FDA-approved for systemic use in patients with noninfectious intermediate, posterior or panuveitis (Figure 3).19 This medication can reduce the rate of treatment failure by 43 to 87 percent in patients with inactive and active uveitis, respectively.
Moreover, adalimumab decreased the risk of UME formation by 67 percent and resulted in resolution of edema in up to 70 percent of cases.20 Off-label intravitreal use of adalimumab has also shown effectiveness in reducing UME in a small retrospective series.21 Side effects include increased risk of infection, lymphoma, heart failure and demyelinating disease.
- Tocilizumab. This monoclonal antibody (Actemra, Genentech) targets interleukin 6, and is used to control inflammation and refractory uveitis. A multicenter retrospective study compared the efficacy of tocilizumab with an anti-TNF agent, infliximab (Remicade, Janssen Biotech).22 This study found tocilizumab to be more effective for controlling and achieving complete resolution of UME (Figure 4). Side effects included infections, elevated liver enzymes and hypertension.
|
| Figure 4. A 16-year-old girl had pars planitis and macular edema in both eyes. The edema (A) didn’t respond well to infliximab (Remicade, Janssen Biotech) and adalimumab (Humira, AbbVie). The patient was switched to tocilizumab (Actemra, Genentech) and the macular edema resolved after two months (B). |
Bottom line
Various systemic and local treatment options are available to manage uveitic macular edema, the most common cause of vision loss in these patients. RS
REFERENCES
1. Durrani OM, Tehrani NN, Marr JE, Moradi P, Stavrou P, Murray PI. Degree, duration, and causes of visual loss in uveitis. Br J Ophthalmol. 2004;88:1159-1162.
2. Tomkins-Netzer O, Talat L, Bar A, et al. Long-term clinical outcome and causes of vision loss in patients with uveitis. Ophthalmology. 2014;121:2387-2392.
3. Chen S, Kong J, Feng L. The trend of drug therapy on uveitic macular edema: A bibliometric analysis of the 100 most cited articles. Front Med (Lausanne). 2022;9:807319.
4. Markomichelakis NN, Halkiadakis I, Pantelia E, et al. Patterns of macular edema in patients with uveitis: Qualitative and quantitative assessment using optical coherence tomography. Ophthalmology. 2004;111:946-953.
5. Iannetti L, Accorinti M, Liverani M, Caggiano C, Abdulaziz R, Pivetti-Pezzi P. Optical coherence tomography for classification and clinical evaluation of macular edema in patients with uveitis. Ocul Immunol Inflamm. 2008;16:155-160.
6. Okhravi N, Lightman S. Cystoid macular edema in uveitis. Ocul Immunol Inflamm. 2003;11:29-38.
7. Goldhardt R, Rosen BS. Uveitic Macular edema: Treatment update. Curr Ophthalmol Rep. 2016;4:30-37.
8. Feiler DL, Srivastava SK, Pichi F, Bena J, Lowder CY. Resolution of noninfectious uveitic cystoid macular edema with topical difluprednate. Retina. 2017;37:844-850.
9. Thorne JE, Sugar EA, Holbrook JT, et al. Periocular triamcinolone vs. intravitreal triamcinolone vs. intravitreal dexamethasone implant for the treatment of uveitic macular edema: The PeriOcular vs. INTravitreal corticosteroids for uveitic macular edema (POINT) Trial. Ophthalmology. 2019;126:283-295.
10. Jaffe GJ, Foster CS, Pavesio CE, Paggiarino DA, Riedel GE. Effect of an injectable fluocinolone acetonide insert on recurrence rates in chronic noninfectious uveitis affecting the posterior segment: Twelve-month results. Ophthalmology. 2019;126:601-610.
11. Alimera Sciences receives acceptance of filing to obtain approval for Iluvien uveitis indication in Europe [press release]. Atlanta, GA:Alimera Sciences; March 25, 2019. https://investors.alimerasciences.com/prviewer/release_only/id/3700779 Accessed April 18, 2022.
12. Studsgaard A, Clemmensen K, Nielsen MS. Intravitreal fluocinolone acetonide 0.19 mg (Iluvien) for the treatment of uveitic macular edema: 2-year follow-up of 20 patients. Graefes Arch Clin Exp Ophthalmol. 2022;260:1633-1639.
13. Writing Committee for the Multicenter Uveitis Steroid Treatment (MUST) Trial and Follow-up Study Research Group; Kempen JH, Altaweel MM, Holbrook JT, Sugar EA, Thorne JE, Jabs DA. Association between long-lasting intravitreous fluocinolone acetonide implant vs systemic anti-inflammatory therapy and visual acuity at 7 years among patients with intermediate, posterior, or panuveitis. JAMA. 2017;317:1993-2005.
14. Bausch + Lomb and Clearside Biomedical announce FDA approval of Xipere (triamcinolone acetonide injectable suspension) for suprachoroidal use for the treatment of macular edema associated with uveitis [press release]. Laval, QC, and Alpharetta, GA: Bausch Health Companies and Clearside Biomedical; October 25, 2021. https://www.prnewswire.com/news-releases/bausch--lomb-and-clearside-biomedical-announce-fda-approval-of-xipere-triamcinolone-acetonide-injectable-suspension-for-suprachoroidal-use-for-the-treatment-of-macular-edema-associated-with-uveitis-301407260.html Accessed April 18, 2022.
15. Yeh S, Khurana R, Shah M, et al. Efficacy and safety of suprachoroidal CLS-TA for macular edema secondary to noninfectious uveitis: Phase 3 randomized trial. Ophthalmology. 2020;127:948-955.
16. Staurenghi G, Lai TYY, Mitchell P, et al. Efficacy and safety of ranibizumab 0.5 mg for the treatment of macular edema resulting from uncommon causes: Twelve-month findings from PROMETHEUS. Ophthalmology. 2018;125:850-862.
17. Rathinam SR, Gonzales JA, Thundikandy R, et al. Effect of corticosteroid-sparing treatment with mycophenolate mofetil vs methotrexate on inflammation in patients with uveitis: A randomized clinical trial. JAMA. 2019;322:936-945.
18. Tsui E, Rathinam SR, Gonzales JA, et al. Outcomes of uveitic macular edema in the first-line antimetabolites as steroid-sparing treatment uveitis trial. Ophthalmology. Published online February 8, 2022.
19. AbbVie’s HUMIRA (adalimumab) receives U.S. Food and Drug Administration approval to treat adults with non-infectious intermediate, posterior and panuveitis [press release]. North Chicago, IL; AbbVie News Center: Jun 30, 2016. https://news.abbvie.com/news/abbvies-humira-adalimumab-receives-us-food-and-drug-administration-approval-to-treat-adults-with-non-infectious-intermediate-posterior-and-panuveitis.htm. Accessed April 18, 2022.
20. Suhler EB, Thorne JE, Mittal M, et al. Corticosteroid-related adverse events systematically increase with corticosteroid dose in noninfectious intermediate, posterior, or panuveitis: Post hoc analyses from the VISUAL-1 and VISUAL-2 trials. Ophthalmology. 2017;124:1799-1807.
21. Hamam RN, Barikian AW, Antonios RS, et al. Intravitreal adalimumab in active noninfectious uveitis: A pilot study. Ocul Immunol Inflamm. 2016;24:319-326.
22. Leclercq M, Andrillon A, Maalouf G, et al. Anti-tumor necrosis factor α versus tocilizumab in the treatment of refractory uveitic macular edema: A multicenter study from the French Uveitis Network. Ophthalmology. Published Online November 16, 2021.




